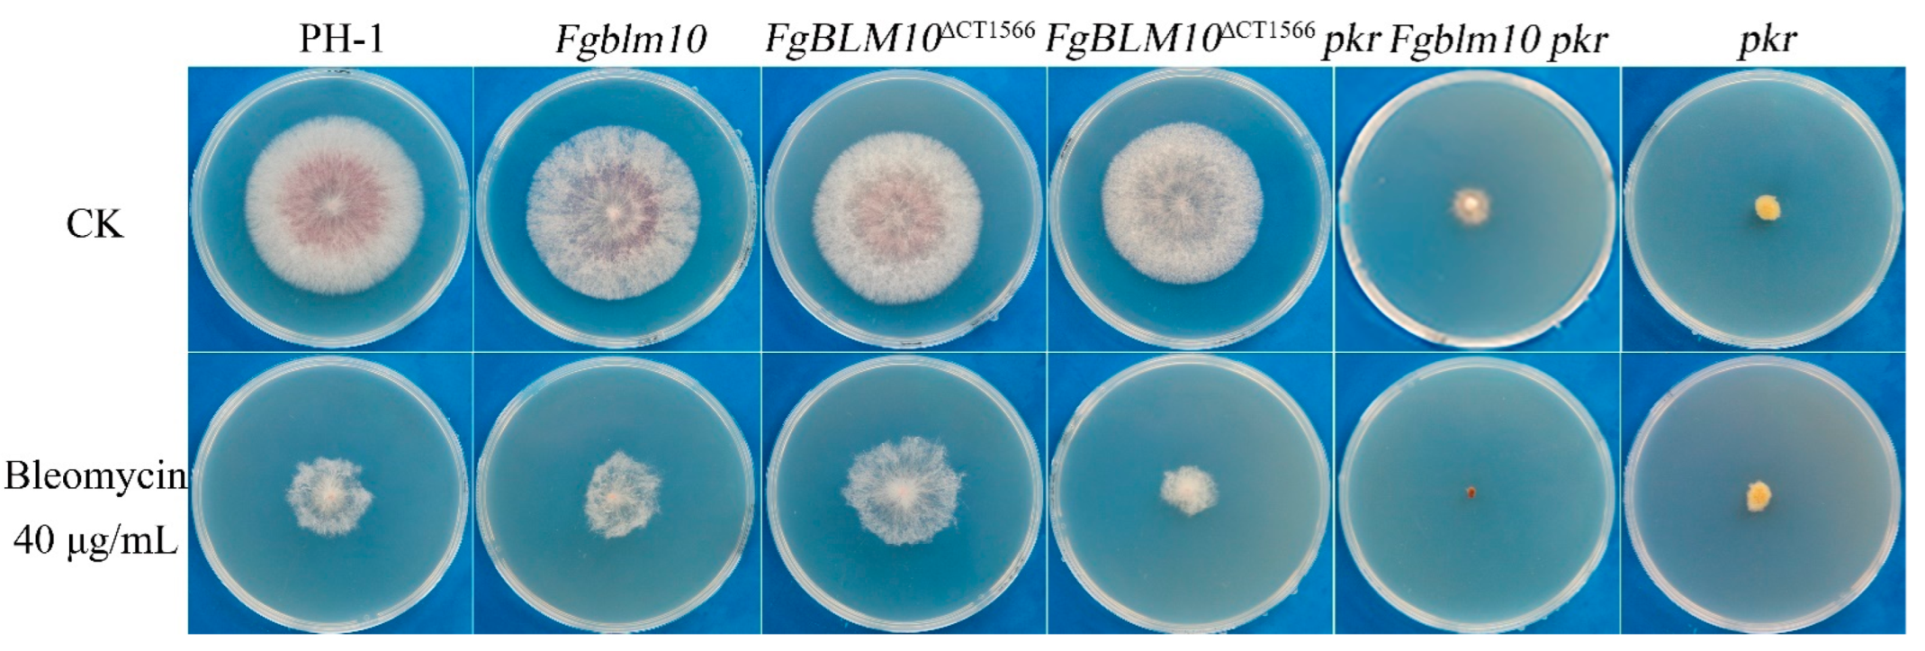

PKR Protects the Major Catalytic Subunit of PKA Cpk1 from FgBlm10-Mediated Proteasome Degradation in Fusarium graminearum
Abstract
1. Introduction
2. Results
2.1. Identification of Suppressor Mutations in FgBlm10, the Activator of 20S Proteasome
2.2. Deletion of FgBlm10 C-Terminus Partially Rescued Growth and Conidiation Defects of the pkr Mutant
2.3. FgBLM10 Is Not Essential for the Growth and Development of F. graminearum
2.4. Two pkr Suppressor Mutations Occur in the α-Ring of the 20S Proteasome
2.5. The C-Terminal Region of FgBlm10 and FgPre5K62 Are Important for Their Interactions
2.6. The C-Terminal Region of FgBlm10 and FgPre6D82 Are Important for Their Interactions
2.7. Pkr Is Important for Protecting Cpk1 from Degradation by the 26S Proteasome
2.8. FgBlm10 Differentially Interacts with the RP and Core Components of the 26S Proteasome in the pkr Mutant and Wild Type
2.9. PKA Indirectly Affects the Phosphorylation Level of FgBlm10
2.10. The Nuclear Localization of FgBlm10 Is Regulated by Its C-Terminus and PKA Activity
2.11. Deletion of the Conserved FgBlm10 C Terminus Results in Bleomycin Resistance
3. Discussion
4. Materials and Methods
4.1. Strains and Culture Conditions
4.2. Generation of the Fgblm10 and FgBLM10ΔCT Deletion Mutants
4.3. Generation FgPRE5K62E and FgPRE6D82N Allele and Transformants
4.4. Plant Infection Assays
4.5. Assays for PKA Activity and Cpk1 Expression
4.6. qRT-PCR Analysis
4.7. Affinity Purification and Mass Spectrometry Analysis
4.8. Co-Immunoprecipitation (co-IP) Assays
4.9. Yeast Two-Hybrid Assays
Supplementary Materials
Author Contributions
Funding
Institutional Review Board Statement
Informed Consent Statement
Data Availability Statement
Acknowledgments
Conflicts of Interest
References
- Witkowska, J.; Gizynska, M.; Grudnik, P.; Golik, P.; Karpowicz, P.; Gieldon, A.; Dubin, G.; Jankowska, E. Crystal structure of a low molecular weight activator Blm-pep with yeast 20S proteasome—insights into the enzyme activation mechanism. Sci. Rep. 2017, 7, 6177. [Google Scholar] [CrossRef] [PubMed]
- Fort, P.; Kajava, A.V.; Delsuc, F.; Coux, O. Evolution of proteasome regulators in eukaryotes. Genome Biol. Evol. 2015, 7, 1363–1379. [Google Scholar] [CrossRef] [PubMed]
- Gemperline, D.C.; Marshall, R.S.; Lee, K.H.; Zhao, Q.; Hu, W.; McLoughlin, F.; Scalf, M.; Smith, L.M.; Vierstra, R.D. Proteomic analysis of affinity-purified 26S proteasomes identifies a suite of assembly chaperones in Arabidopsis. J. Biol. Chem. 2019, 294, 17570–17592. [Google Scholar] [CrossRef]
- Sadre-Bazzaz, K.; Whitby, F.G.; Robinson, H.; Formosa, T.; Hill, C.P. Structure of a Blm10 complex reveals common mechanisms for proteasome binding and gate opening. Mol. Cell 2010, 37, 728–735. [Google Scholar] [CrossRef] [PubMed]
- Ustrell, V.; Hoffman, L.; Pratt, G.; Rechsteiner, M. PA200, a nuclear proteasome activator involved in DNA repair. EMBO J. 2002, 21, 3516–3525. [Google Scholar] [CrossRef] [PubMed]
- Ma, C.P.; Slaughter, C.A.; DeMartino, G.N. Identification, purification, and characterization of a protein activator (PA28) of the 20 S proteasome (macropain). J. Biol. Chem. 1992, 267, 10515–10523. [Google Scholar] [CrossRef]
- Masson, P.; Lundin, D.; Söderbom, F.; Young, P. Characterization of a REG/PA28 proteasome activator homolog in Dictyostelium discoideum indicates that the ubiquitin- and ATP-independent REGgamma proteasome is an ancient nuclear protease. Eukaryot. Cell 2009, 8, 844–851. [Google Scholar] [CrossRef]
- Chu-Ping, M.; Vu, J.H.; Proske, R.J.; Slaughter, C.A.; DeMartino, G.N. Identification, purification, and characterization of a high molecular weight, ATP-dependent activator (PA700) of the 20 S proteasome. J. Biol. Chem. 1994, 269, 3539–3547. [Google Scholar] [CrossRef]
- Stadtmueller, B.M.; Hill, C.P. Proteasome activators. Mol. Cell 2011, 41, 8–19. [Google Scholar] [CrossRef]
- Aladdin, A.; Yao, Y.; Yang, C.; Kahlert, G.; Ghani, M.; Király, N.; Boratkó, A.; Uray, K.; Dittmar, G.; Tar, K. The Proteasome Activators Blm10/PA200 Enhance the Proteasomal Degradation of N-Terminal Huntingtin. Biomolecules 2020, 10, 1581. [Google Scholar] [CrossRef]
- Stadtmueller, B.M.; Kish-Trier, E.; Ferrell, K.; Petersen, C.N.; Robinson, H.; Myszka, D.G.; Eckert, D.M.; Formosa, T.; Hill, C.P. Structure of a proteasome Pba1-Pba2 complex: Implications for proteasome assembly, activation, and biological function. J. Biol. Chem. 2012, 287, 37371–37382. [Google Scholar] [CrossRef] [PubMed]
- Li, X.; Thompson, D.; Kumar, B.; DeMartino, G.N. Molecular and cellular roles of PI31 (PSMF1) protein in regulation of proteasome function. J. Biol. Chem. 2014, 289, 17392–17405. [Google Scholar] [CrossRef]
- Burris, A.; Waite, K.A.; Reuter, Z.; Ockerhausen, S.; Roelofs, J. Proteasome activator Blm10 levels and autophagic degradation directly impact the proteasome landscape. J. Biol. Chem. 2021, 296, 100468. [Google Scholar] [CrossRef] [PubMed]
- Savulescu, A.F.; Glickman, M.H. Proteasome activator 200: The heat is on. Mol. Cell. Proteom. 2011, 10, R110.006890. [Google Scholar] [CrossRef]
- Dange, T.; Smith, D.; Noy, T.; Rommel, P.C.; Jurzitza, L.; Cordero, R.J.; Legendre, A.; Finley, D.; Goldberg, A.L.; Schmidt, M. Blm10 protein promotes proteasomal substrate turnover by an active gating mechanism. J. Biol. Chem. 2011, 286, 42830–42839. [Google Scholar] [CrossRef] [PubMed]
- Chen, Y.S.; Han, X.; Lin, K.; Jiang, T.X.; Qiu, X.B. Proteasome Activator Blm10 Regulates Transcription Especially During Aging. Curr. Genom. 2021, 22, 306–317. [Google Scholar] [CrossRef] [PubMed]
- Qian, M.X.; Pang, Y.; Liu, C.H.; Haratake, K.; Du, B.Y.; Ji, D.Y.; Wang, G.F.; Zhu, Q.Q.; Song, W.; Yu, Y.; et al. Acetylation-mediated proteasomal degradation of core histones during DNA repair and spermatogenesis. Cell 2013, 153, 1012–1024. [Google Scholar] [CrossRef]
- Chowdhury, M.; Enenkel, C. Intracellular Dynamics of the Ubiquitin-Proteasome-System. F1000Research 2015, 4, 367. [Google Scholar] [CrossRef]
- Lopez, A.D.; Tar, K.; Krügel, U.; Dange, T.; Ros, I.G.; Schmidt, M. Proteasomal degradation of Sfp1 contributes to the repression of ribosome biogenesis during starvation and is mediated by the proteasome activator Blm10. Mol. Biol. Cell 2011, 22, 528–540. [Google Scholar] [CrossRef]
- Fehlker, M.; Wendler, P.; Lehmann, A.; Enenkel, C. Blm3 is part of nascent proteasomes and is involved in a late stage of nuclear proteasome assembly. EMBO Rep. 2003, 4, 959–963. [Google Scholar] [CrossRef]
- Marques, A.J.; Glanemann, C.; Ramos, P.C.; Dohmen, R.J. The C-terminal extension of the beta7 subunit and activator complexes stabilize nascent 20 S proteasomes and promote their maturation. J. Biol. Chem. 2007, 282, 34869–34876. [Google Scholar] [CrossRef] [PubMed]
- Weberruss, M.H.; Savulescu, A.F.; Jando, J.; Bissinger, T.; Harel, A.; Glickman, M.H.; Enenkel, C. Blm10 facilitates nuclear import of proteasome core particles. EMBO J. 2013, 32, 2697–2707. [Google Scholar] [CrossRef] [PubMed]
- Marshall, R.S.; Vierstra, R.D. Proteasome storage granules protect proteasomes from autophagic degradation upon carbon starvation. Elife 2018, 7, e34532. [Google Scholar] [CrossRef]
- Turrà, D.; Segorbe, D.; Di Pietro, A. Protein kinases in plant-pathogenic fungi: Conserved regulators of infection. Annu. Rev. Phytopathol. 2014, 52, 267–288. [Google Scholar] [CrossRef] [PubMed]
- Lee, N.; D’Souza, C.A.; Kronstad, J.W. Of smuts, blasts, mildews, and blights: cAMP signaling in phytopathogenic fungi. Annu. Rev. Phytopathol. 2003, 41, 399–427. [Google Scholar] [CrossRef]
- Li, Y.; Zhang, X.; Hu, S.; Liu, H.; Xu, J.R. PKA activity is essential for relieving the suppression of hyphal growth and appressorium formation by MoSfl1 in Magnaporthe oryzae. PLoS Genet. 2017, 13, e1006954. [Google Scholar] [CrossRef]
- Anand, G.; Taylor, S.S.; Johnson, D.A. Cyclic-AMP and pseudosubstrate effects on type-I A-kinase regulatory and catalytic subunit binding kinetics. Biochemistry 2007, 46, 9283–9291. [Google Scholar] [CrossRef]
- Tillo, S.E.; Xiong, W.H.; Takahashi, M.; Miao, S.; Andrade, A.L.; Fortin, D.A.; Yang, G.; Qin, M.; Smoody, B.F.; Stork, P.J.S.; et al. Liberated PKA Catalytic Subunits Associate with the Membrane via Myristoylation to Preferentially Phosphorylate Membrane Substrates. Cell Rep. 2017, 19, 617–629. [Google Scholar] [CrossRef]
- Walker-Gray, R.; Stengel, F.; Gold, M.G. Mechanisms for restraining cAMP-dependent protein kinase revealed by subunit quantitation and cross-linking approaches. Proc. Natl. Acad. Sci. USA 2017, 114, 10414–10419. [Google Scholar] [CrossRef]
- Gold, M.G. Swimming regulations for protein kinase A catalytic subunit. Biochem. Soc. Trans. 2019, 47, 1355–1366. [Google Scholar] [CrossRef]
- Newhall, K.J.; Cummings, D.E.; Nolan, M.A.; McKnight, G.S. Deletion of the RIIβ-Subunit of Protein Kinase A Decreases Body Weight and Increases Energy Expenditure in the Obese, Leptin-Deficient ob/ob Mouse. Mol. Endocrinol. 2005, 19, 982–991. [Google Scholar] [CrossRef] [PubMed][Green Version]
- Cummings, D.E.; Brandon, E.P.; Planas, J.V.; Motamed, K.; Idzerda, R.L.; McKnight, G.S. Genetically lean mice result from targeted disruption of the RIIβ subunit of protein kinase A. Nature 1996, 382, 622–626. [Google Scholar] [CrossRef] [PubMed]
- Nguyen, E.; Gausdal, G.; Varennes, J.; Pendino, F.; Lanotte, M.; Døskeland, S.O.; Ségal-Bendirdjian, E. Activation of both protein kinase A (PKA) type I and PKA type II isozymes is required for retinoid-induced maturation of acute promyelocytic leukemia cells. Mol. Pharmacol. 2013, 83, 1057–1065. [Google Scholar] [CrossRef] [PubMed]
- Rinaldi, J.; Wu, J.; Yang, J.; Ralston, C.Y.; Sankaran, B.; Moreno, S.; Taylor, S.S. Structure of yeast regulatory subunit: A glimpse into the evolution of PKA signaling. Structure 2010, 18, 1471–1482. [Google Scholar] [CrossRef]
- Canaves, J.M.; Taylor, S.S. Classification and phylogenetic analysis of the cAMP-dependent protein kinase regulatory subunit family. J. Mol. Evol. 2002, 54, 17–29. [Google Scholar] [CrossRef]
- Li, C.; Zhang, Y.; Wang, H.; Chen, L.; Zhang, J.; Sun, M.; Xu, J.R.; Wang, C. The PKR regulatory subunit of protein kinase A (PKA) is involved in the regulation of growth, sexual and asexual development, and pathogenesis in Fusarium graminearum. Mol. Plant Pathol. 2018, 19, 909–921. [Google Scholar] [CrossRef]
- Takano, Y.; Komeda, K.; Kojima, K.; Okuno, T. Proper regulation of cyclic AMP-dependent protein kinase is required for growth, conidiation, and appressorium function in the anthracnose fungus Colletotrichum lagenarium. Mol. Plant-Microbe Interact. 2001, 14, 1149–1157. [Google Scholar] [CrossRef]
- Hirose, S.; Katoh-Kurasawa, M.; Shaulsky, G. Cyclic AMP is dispensable for allorecognition in Dictyostelium cells overexpressing PKA-C. J. Cell Sci. 2021, 134, jcs258777. [Google Scholar] [CrossRef]
- Loomis, W.F. Role of PKA in the Timing of Developmental Events in Dictyostelium Cells. Microbiol. Mol. Biol. Rev. 1998, 62, 684–694. [Google Scholar] [CrossRef]
- Boundy, V.A.; Chen, J.; Nestler, E.J. Regulation of cAMP-dependent protein kinase subunit expression in CATH.a and SH-SY5Y cells. J. Pharmacol. Exp. Ther. 1998, 286, 1058–1065. [Google Scholar]
- VerPlank, J.J.S.; Lokireddy, S.; Zhao, J.; Goldberg, A.L. 26S Proteasomes are rapidly activated by diverse hormones and physiological states that raise cAMP and cause Rpn6 phosphorylation. Proc. Natl. Acad. Sci. USA 2019, 116, 4228–4237. [Google Scholar] [CrossRef] [PubMed]
- Hu, S.; Zhou, X.; Gu, X.; Cao, S.; Wang, C.; Xu, J.R. The cAMP-PKA pathway regulates growth, sexual and asexual differentiation, and pathogenesis in Fusarium graminearum. Mol. Plant-Microbe Interact. 2014, 27, 557–566. [Google Scholar] [CrossRef] [PubMed]
- Cuomo, C.A.; Gueldener, U.; Xu, J.R.; Trail, F.; Turgeon, B.G.; Di Pietro, A.; Walton, J.D.; Ma, L.J.; Baker, S.E.; Rep, M.; et al. The Fusarium graminearum genome reveals a link between localized polymorphism and pathogen specialization. Science 2007, 317, 1400–1402. [Google Scholar] [CrossRef] [PubMed]
- Finley, D.; Ulrich, H.D.; Sommer, T.; Kaiser, P. The ubiquitin-proteasome system of Saccharomyces cerevisiae. Genetics 2012, 192, 319–360. [Google Scholar] [CrossRef]
- Ortega, J.; Heymann, J.B.; Kajava, A.V.; Ustrell, V.; Rechsteiner, M.; Steven, A.C. The axial channel of the 20S proteasome opens upon binding of the PA200 activator. J. Mol. Biol. 2005, 346, 1221–1227. [Google Scholar] [CrossRef]
- Löwe, J.; Stock, D.; Jap, B.; Zwickl, P.; Baumeister, W.; Huber, R. Crystal structure of the 20S proteasome from the archaeon T. acidophilum at 3.4 A resolution. Science 1995, 268, 533–539. [Google Scholar] [CrossRef]
- Schmidt, M.; Haas, W.; Crosas, B.; Santamaria, P.G.; Gygi, S.P.; Walz, T.; Finley, D. The HEAT repeat protein Blm10 regulates the yeast proteasome by capping the core particle. Nat. Struct. Mol. Biol. 2005, 12, 294–303. [Google Scholar] [CrossRef]
- Bard, J.A.M.; Goodall, E.A.; Greene, E.R.; Jonsson, E.; Dong, K.C.; Martin, A. Structure and Function of the 26S Proteasome. Annu. Rev. Biochem. 2018, 87, 697–724. [Google Scholar] [CrossRef]
- Groll, M.; Heinemeyer, W.; Jäger, S.; Ullrich, T.; Bochtler, M.; Wolf, D.H.; Huber, R. The catalytic sites of 20S proteasomes and their role in subunit maturation: A mutational and crystallographic study. Proc. Natl. Acad. Sci. USA 1999, 96, 10976–10983. [Google Scholar] [CrossRef]
- Hsu, C.-C.; Zhu, Y.; Arrington, J.V.; Paez, J.S.; Wang, P.; Zhu, P.; Chen, I.-H.; Zhu, J.-K.; Tao, W.A. Universal plant phosphoproteomics workflow and its application to tomato signaling in response to cold stress. Mol. Cell. Proteom. 2018, 17, 2068–2080. [Google Scholar] [CrossRef]
- Hu, L.; Zhou, H.; Li, Y.; Sun, S.; Guo, L.; Ye, M.; Tian, X.; Gu, J.; Yang, S.; Zou, H. Profiling of endogenous serum phosphorylated peptides by titanium (IV) immobilized mesoporous silica particles enrichment and MALDI-TOFMS detection. Anal. Chem. 2009, 81, 94–104. [Google Scholar] [CrossRef]
- Wendler, P.; Enenkel, C. Nuclear Transport of Yeast Proteasomes. Front. Mol. Biosci. 2019, 6, 34. [Google Scholar] [CrossRef] [PubMed]
- Enenkel, C. Nuclear transport of yeast proteasomes. Biomolecules 2014, 4, 940–955. [Google Scholar] [CrossRef] [PubMed]
- Doherty, K.M.; Pride, L.D.; Lukose, J.; Snydsman, B.E.; Charles, R.; Pramanik, A.; Muller, E.G.; Botstein, D.; Moore, C.W. Loss of a 20S proteasome activator in Saccharomyces cerevisiae downregulates genes important for genomic integrity, increases DNA damage, and selectively sensitizes cells to agents with diverse mechanisms of action. G3 2012, 2, 943–959. [Google Scholar] [CrossRef]
- McCullock, S.; Kinard, T.; McCullough, L.; Formosa, T. blm3-1 is an allele of UBP3, a ubiquitin protease that appears to act during transcription of damaged DNA. J. Mol. Biol. 2006, 363, 660–672. [Google Scholar] [CrossRef]
- McKinney, J.S.; Sethi, S.; Tripp, J.D.; Nguyen, T.N.; Sanderson, B.A.; Westmoreland, J.W.; Resnick, M.A.; Lewis, L.K. A multistep genomic screen identifies new genes required for repair of DNA double-strand breaks in Saccharomyces cerevisiae. BMC Genom. 2013, 14, 251. [Google Scholar] [CrossRef] [PubMed]
- Ding, X.; Cao, C.; Zheng, Q.; Huang, G. The Regulatory Subunit of Protein Kinase A (Bcy1) in Candida albicans Plays Critical Roles in Filamentation and White-Opaque Switching but Is Not Essential for Cell Growth. Front. Microbiol. 2017, 7, 2127. [Google Scholar] [CrossRef]
- Selvaraj, P.; Tham, H.F.; Ramanujam, R.; Naqvi, N.I. Subcellular compartmentation, interdependency and dynamics of the cyclic AMP-dependent PKA subunits during pathogenic differentiation in rice blast. Mol. Microbiol. 2017, 105, 484–504. [Google Scholar] [CrossRef]
- Hu, G.; Steen, B.R.; Lian, T.; Sham, A.P.; Tam, N.; Tangen, K.L.; Kronstad, J.W. Transcriptional regulation by protein kinase A in Cryptococcus neoformans. PLoS Pathog. 2007, 3, e42. [Google Scholar] [CrossRef]
- Budhwar, R.; Lu, A.; Hirsch, J.P. Nutrient control of yeast PKA activity involves opposing effects on phosphorylation of the Bcy1 regulatory subunit. Mol. Biol. Cell 2010, 21, 3749–3758. [Google Scholar] [CrossRef][Green Version]
- Haushalter, K.J.; Casteel, D.E.; Raffeiner, A.; Stefan, E.; Patel, H.H.; Taylor, S.S. Phosphorylation of protein kinase A (PKA) regulatory subunit RIα by protein kinase G (PKG) primes PKA for catalytic activity in cells. J. Biol. Chem. 2018, 293, 4411–4421. [Google Scholar] [CrossRef] [PubMed]
- Tanaka, K.; Mizushima, T.; Saeki, Y. The proteasome: Molecular machinery and pathophysiological roles. Biol. Chem. 2012, 393, 217–234. [Google Scholar] [CrossRef] [PubMed]
- Wang, X.; Meul, T.; Meiners, S. Exploring the proteasome system: A novel concept of proteasome inhibition and regulation. Pharmacol. Ther. 2020, 211, 107526. [Google Scholar] [CrossRef]
- Kim, S.T.; Yu, S.; Kim, S.G.; Kim, H.J.; Kang, S.Y.; Hwang, D.H.; Jang, Y.S.; Kang, K.Y. Proteome analysis of rice blast fungus (Magnaporthe grisea) proteome during appressorium formation. Proteomics 2004, 4, 3579–3587. [Google Scholar] [CrossRef]
- Otoda, T.; Takamura, T.; Misu, H.; Ota, T.; Murata, S.; Hayashi, H.; Takayama, H.; Kikuchi, A.; Kanamori, T.; Shima, K.R. Proteasome dysfunction mediates obesity-induced endoplasmic reticulum stress and insulin resistance in the liver. Diabetes 2013, 62, 811–824. [Google Scholar] [CrossRef] [PubMed]
- Chen, L.B.; Ma, S.; Jiang, T.X.; Qiu, X.B. Transcriptional upregulation of proteasome activator Blm10 antagonizes cellular aging. Biochem. Biophys. Res. Commun. 2020, 532, 211–218. [Google Scholar] [CrossRef]
- Pergolizzi, B.; Bozzaro, S.; Bracco, E. Dictyostelium as model for studying ubiquitination and deubiquitination. Int. J. Dev. Biol. 2019, 63, 529–539. [Google Scholar] [CrossRef]
- Xiong, Q.; Fischer, S.; Karow, M.; Müller, R.; Meling, S. ATG16 mediates the autophagic degradation of the 19S proteasomal subunits PSMD1 and PSMD2. Eur. J. Cell Biol. 2018, 97, 523–532. [Google Scholar] [CrossRef]
- Karow, M.; Fischer, S.; Konertz, R.; Riehl, J.; Xiong, Q.; Rijal, R.; Wagle, P.; Clemen, C.S.; Eichinger, L. Functional Characterisation of the Autophagy ATG12~5/16 Complex in Dictyostelium discoideum. Cells 2020, 9, 1179. [Google Scholar] [CrossRef]
- VerPlank, J.J.S.; Goldberg, A.L. Regulating protein breakdown through proteasome phosphorylation. Biochem. J. 2017, 474, 3355–3371. [Google Scholar] [CrossRef]
- Lokireddy, S.; Kukushkin, N.V.; Goldberg, A.L. cAMP-induced phosphorylation of 26S proteasomes on Rpn6/PSMD11 enhances their activity and the degradation of misfolded proteins. Proc. Natl. Acad. Sci. USA 2015, 112, E7176–E7185. [Google Scholar] [CrossRef] [PubMed]
- Guo, X.; Huang, X.; Chen, M.J. Reversible phosphorylation of the 26S proteasome. Protein Cell 2017, 8, 255–272. [Google Scholar] [CrossRef] [PubMed]
- Zhang, F.; Hu, Y.; Huang, P.; Toleman, C.A.; Paterson, A.J.; Kudlow, J.E. Proteasome function is regulated by cyclic AMP-dependent protein kinase through phosphorylation of Rpt6. J. Biol. Chem. 2007, 282, 22460–22471. [Google Scholar] [CrossRef] [PubMed]
- Myeku, N.; Wang, H.; Figueiredo-Pereira, M.E. cAMP stimulates the ubiquitin/proteasome pathway in rat spinal cord neurons. Neurosci. Lett. 2012, 527, 126–131. [Google Scholar] [CrossRef]
- Lin, J.T.; Chang, W.C.; Chen, H.M.; Lai, H.L.; Chen, C.Y.; Tao, M.H.; Chern, Y. Regulation of feedback between protein kinase A and the proteasome system worsens Huntington’s disease. Mol. Cell Biol. 2013, 33, 1073–1084. [Google Scholar] [CrossRef]
- Wang, C.; Zhang, S.; Hou, R.; Zhao, Z.; Zheng, Q.; Xu, Q.; Zheng, D.; Wang, G.; Liu, H.; Gao, X.; et al. Functional analysis of the kinome of the wheat scab fungus Fusarium graminearum. PLoS Pathog. 2011, 7, e1002460. [Google Scholar] [CrossRef]
- Yin, J.; Hao, C.; Niu, G.; Wang, W.; Wang, G.; Xiang, P.; Xu, J.R.; Zhang, X. FgPal1 regulates morphogenesis and pathogenesis in Fusarium graminearum. Environ. Microbiol. 2020, 22, 5373–5386. [Google Scholar] [CrossRef]
- Sun, M.; Zhang, Y.; Wang, Q.; Wu, C.; Jiang, C.; Xu, J.R. The tri-snRNP specific protein FgSnu66 is functionally related to FgPrp4 kinase in Fusarium graminearum. Mol. Microbiol. 2018, 109, 494–508. [Google Scholar] [CrossRef]
- Hou, Z.; Xue, C.; Peng, Y.; Katan, T.; Kistler, H.C.; Xu, J.R. A mitogen-activated protein kinase gene (MGV1) in Fusarium graminearum is required for female fertility, heterokaryon formation, and plant infection. Mol. Plant-Microbe Interact. 2002, 15, 1119–1127. [Google Scholar] [CrossRef]
- Zhou, X.; Li, G.; Xu, J.R. Efficient approaches for generating GFP fusion and epitope-tagging constructs in filamentous fungi. Methods Mol. Biol. 2011, 722, 199–212. [Google Scholar] [CrossRef]
- Zheng, W.; Lin, Y.; Fang, W.; Zhao, X.; Lou, Y.; Wang, G.; Zheng, H.; Liang, Q.; Abubakar, Y.S.; Olsson, S.; et al. The endosomal recycling of FgSnc1 by FgSnx41-FgSnx4 heterodimer is essential for polarized growth and pathogenicity in Fusarium graminearum. New Phytol. 2018, 219, 654–671. [Google Scholar] [CrossRef] [PubMed]
- King, R.; Urban, M.; Hammond-Kosack, M.C.; Hassani-Pak, K.; Hammond-Kosack, K.E. The completed genome sequence of the pathogenic ascomycete fungus Fusarium graminearum. BMC Genom. 2015, 16, 544. [Google Scholar] [CrossRef]
- Yin, T.; Zhang, Q.; Wang, J.; Liu, H.; Wang, C.; Xu, J.R.; Jiang, C. The cyclase-associated protein FgCap1 has both protein kinase A-dependent and -independent functions during deoxynivalenol production and plant infection in Fusarium graminearum. Mol. Plant Pathol. 2018, 19, 552–563. [Google Scholar] [CrossRef]
- Jiang, C.; Cao, S.; Wang, Z.; Xu, H.; Liang, J.; Liu, H.; Wang, G.; Ding, M.; Wang, Q.; Gong, C.; et al. An expanded subfamily of G-protein-coupled receptor genes in Fusarium graminearum required for wheat infection. Nat. Microbiol. 2019, 4, 1582–1591. [Google Scholar] [CrossRef] [PubMed]
- Jiang, C.; Zhang, C.; Wu, C.; Sun, P.; Hou, R.; Liu, H.; Wang, C.; Xu, J.R. TRI6 and TRI10 play different roles in the regulation of deoxynivalenol (DON) production by cAMP signalling in Fusarium graminearum. Env. Microbiol. 2016, 18, 3689–3701. [Google Scholar] [CrossRef]
- Hou, L.; Li, B.; Ding, D.; Kang, L.; Wang, X. CREB-B acts as a key mediator of NPF/NO pathway involved in phase-related locomotor plasticity in locusts. PLoS Genet. 2019, 15, e1008176. [Google Scholar]
- Zhou, X.; Zhang, H.; Li, G.; Shaw, B.; Xu, J.R. The Cyclase-associated protein Cap1 is important for proper regulation of infection-related morphogenesis in Magnaporthe oryzae. PLoS Pathog. 2012, 8, e1002911. [Google Scholar] [CrossRef]
- Liu, H.; Zhang, S.; Ma, J.; Dai, Y.; Li, C.; Lyu, X.; Wang, C.; Xu, J.R. Two Cdc2 kinase genes with distinct functions in vegetative and infectious hyphae in Fusarium graminearum. PLoS Pathog. 2015, 11, e1004913. [Google Scholar] [CrossRef][Green Version]
- Wang, H.; Chen, D.; Li, C.; Tian, N.; Zhang, J.; Xu, J.R.; Wang, C. Stage-specific functional relationships between Tub1 and Tub2 beta-tubulins in the wheat scab fungus Fusarium graminearum. Fungal Genet. Biol. 2019, 132, 103251. [Google Scholar] [CrossRef]
- Jiang, H.; Xia, A.; Ye, M.; Ren, J.; Li, D.; Liu, H.; Wang, Q.; Lu, P.; Wu, C.; Xu, J.R.; et al. Opposing functions of Fng1 and the Rpd3 HDAC complex in H4 acetylation in Fusarium graminearum. PLoS Genet. 2020, 16, e1009185. [Google Scholar] [CrossRef]
- Ding, S.L.; Liu, W.; Iliuk, A.; Ribot, C.; Vallet, J.; Tao, A.; Wang, Y.; Lebrun, M.H.; Xu, J.R. The Tig1 histone deacetylase complex regulates infectious growth in the rice blast fungus Magnaporthe oryzae. Plant Cell 2010, 22, 2495–2508. [Google Scholar] [CrossRef]
- Liu, W.; Iliuk, A.; Tao, A.; Ding, S. Identifying protein complexes by affinity purification and mass spectrometry analysis in the rice blast fungus. Methods Mol. Biol. 2011, 722, 157–166. [Google Scholar] [CrossRef] [PubMed]
- Tao, W.A.; Wollscheid, B.; O’Brien, R.; Eng, J.K.; Li, X.J.; Bodenmiller, B.; Watts, J.D.; Hood, L.; Aebersold, R. Quantitative phosphoproteome analysis using a dendrimer conjugation chemistry and tandem mass spectrometry. Nat. Methods 2005, 2, 591–598. [Google Scholar] [CrossRef] [PubMed]
- Zhou, F.; Galan, J.; Geahlen, R.L.; Tao, W.A. A novel quantitative proteomics strategy to study phosphorylation-dependent peptide-protein interactions. J. Proteome Res. 2007, 6, 133–140. [Google Scholar] [CrossRef] [PubMed]
- Tabb, D.L.; Eng, J.K.; Yates, J.R. Protein Identification by SEQUEST. In Proteome Research: Mass Spectrometry; Springer: Berlin/Heidelberg, Germany, 2001; pp. 125–142. [Google Scholar]
- Wang, Z.; Ma, T.; Huang, Y.; Wang, J.; Yin, Y. A fungal ABC transporter FgAtm1 regulates iron homeostasis via the transcription factor cascade FgAreA-HapX. PLoS Pathog. 2019, 15, e1007791. [Google Scholar]
- Yang, C.; Liu, H.; Li, G.; Liu, M.; Yun, Y.; Wang, C.; Ma, Z.; Xu, J. The MADS-box transcription factor FgMcm1 regulates cell identity and fungal development in Fusarium graminearum. Environ. Microbiol. 2015, 17, 2762–2776. [Google Scholar] [CrossRef]
- Adachi, K.; Hamer, J.E. Divergent cAMP signaling pathways regulate growth and pathogenesis in the rice blast fungus Magnaporthe grisea. Plant Cell 1998, 10, 1361–1374. [Google Scholar] [CrossRef]

| Suppressor Strain | Predicted Gene | Yeast Ortholog | Mutations | |
|---|---|---|---|---|
| DNA | Protein | |||
| FgPRE5, FgPRE6, and FgBLM10 mutations identified by whole genome sequencing analysis | ||||
| H4 | FGRRES_07282 | PRE6 | G410 to A | D82N |
| H6 | FGRRES_05222 | PRE5 | A325 to G | K62E |
| H10 | FGRRES_16648 | BLM10 | ΔT1220-C3362 | S392fs |
| H11 | FGRRES_16648 | BLM10 | ΔG4185 | G1380fs |
| FGRRES_00324 | SNT1 | Insertion of a T after C6065 | A1958fs | |
| Mutations identified by amplifying and sequencing FgBLM10 | ||||
| H9 | FGRRES_16648 | BLM10 | C986 to T986 | Q314 * |
| H25 | FGRRES_16648 | BLM10 | ΔC997 | L317fs |
| H13 | FGRRES_16648 | BLM10 | ΔT1220-C3362 | S392fs |
| H23 | FGRRES_16648 | BLM10 | ΔC1234 | F396fs |
| H47 | FGRRES_16648 | BLM10 | ΔG2327 | N799fs |
| H5 | FGRRES_16648 | BLM10 | C3044 to T3044 | Q1000 * |
| H15 | FGRRES_16648 | BLM10 | ΔC3631 | L1195fs |
| H32 | FGRRES_16648 | BLM10 | ΔC3631 | L1195fs |
| H21 | FGRRES_16648 | BLM10 | ΔC3631 | L1195fs |
| Strains | Brief Description | References |
|---|---|---|
| PH-1 | Wild type | [43] |
| pkr | pkr deletion mutant of PH-1 | [36] |
| H4, H6, H10, H11, H5, H9, H13, H15, H21, H23, H25, H32, H47 | Spontaneous suppressor mutants of pkr mutant | [36] |
| BM1 | Fgblm10 deletion mutant of PH-1 | This study |
| BM5 | Fgblm10 deletion mutant of PH-1 | This study |
| BM13 | Fgblm10 deletion mutant of PH-1 | This study |
| BN3 | FgBLM10∆CT1566 mutant of PH-1 | This study |
| BN6 | FgBLM10∆CT1566 mutant of PH-1 | This study |
| BN9 | FgBLM10∆CT1566 mutant of PH-1 | This study |
| BNP2 | Fgblm10 pkr mutant of PH-1 | This study |
| BNP5 | Fgblm10 pkr mutant of PH-1 | This study |
| BNP10 | Fgblm10 pkr mutant of PH-1 | This study |
| BNP1 | FgBLM10∆CT1566 pkr mutant of PH-1 | This study |
| BNP4 | FgBLM10∆CT1566pkr mutant of PH-1 | This study |
| BNP10 | FgBLM10∆CT1566pkr mutant of PH-1 | This study |
| BNYP4 | FgBLM10∆CT11pkr mutant of PH-1 | This study |
| BNYP10 | FgBLM10∆CT11pkr mutant of PH-1 | This study |
| BPR5-2 | FgBLM10-GFP and FgPRE5-His transformant of PH-1 | This study |
| BPR5-1 | FgBLM10-GFP and FgPRE5-His transformant of PH-1 | This study |
| BPR5-4 | FgBLM10-GFP and FgPRE5-His transformant of PH-1 | This study |
| BPR6-1 | FgBLM10-GFP and FgPRE6-His transformant of PH-1 | This study |
| BPR6-3 | FgBLM10-GFP and FgPRE6-His transformant of PH-1 | This study |
| BPEK3 | FgBLM10-GFP and FgPRE5K62E-His transformant of PH-1 | This study |
| BPEK4 | FgBLM10-GFP and FgPRE5K62E-His transformant of PH-1 | This study |
| BPRD5 | FgBLM10-GFP with FgPRE6D82N -His transformant of PH-1 | This study |
| BPRD7 | FgBLM10-GFP with FgPRE6D82N -His transformant of PH-1 | This study |
| BCPR6-1 | FgBLM10∆CT1566-GFP and FgPRE6-His transformant of PH-1 | This study |
| BCPR6-3 | FgBLM10∆CT1566-GFP and FgPRE6-His transformant of PH-1 | This study |
| BCPR5-3 | FgBLM10∆CT1566-GFP and FgPRE5-His transformant of PH-1 | This study |
| BCPR5-4 | FgBLM10∆CT1566-GFP and FgPRE5-His transformant of PH-1 | This study |
| Strain | Growth Rate(mm/Day) a,b | Conidiation (×104 Conidia/mL) a,c | Disease Index a,d |
|---|---|---|---|
| PH-1 | 10.5 ± 0.3 a | 247.6 ± 24.7 a | 9.8 ± 2.6 a |
| pkr | 2.9 ± 0.4 f | 14.2 ± 2.6 de | 0 ± 0 d |
| Fgblm10∆CT11pkr | 8.3 ± 0.6 b | 10.2 ± 5.6 bc | 0 ± 0 d |
| Fgblm10 | 8.4 ± 0.4 b | 97.9 ± 15.9 b | 6.5 ± 1.5 b |
| Fgblm10∆CT1566 | 7.5 ± 0.2 d | 140.2 ± 23.9 a | 7.7 ± 1.5 b |
| Fgblm10 pkr | 3.2 ± 0.5 f | 46.3 ± 9.3 c | 0.3 ± 0.5 c |
| Fgblm10∆CT1566pkr | 7.9 ± 0.4 c | 49.6 ± 11.1 c | 1.0 ± 0.0 c |
| Genes | Homologs in S. cerevisiae | Function | PSMs | |
|---|---|---|---|---|
| PH-1 | pkr | |||
| FGRRES_16648 | Blm10 | 1341 | 469 | |
| 20S core particle | ||||
| FGRRES_07282_M | PRE6 | α4 | 1 | 1 |
| FGRRES_10255_M | SCL1 | α1 | 2 | 0 |
| FGRRES_04410 | PRE8 | α2 | 2 | 0 |
| FGRRES_05365 | PRE9 | α3 | 1 | 0 |
| FGRRES_01160 | PRE7 | β6 | 1 | 0 |
| 19S regulatory particle | ||||
| FGRRES_07956 | RPN9 | Structural | 21 | 5 |
| FGRRES_08444 | RPN7 | Structural | 12 | 3 |
| FGRRES_01198 | RPT4 | ATPase | 12 | 4 |
| FGRRES_01605 | RPT6 | ATPase | 14 | 2 |
| FGRRES_00306 | RPN6 | Structural | 19 | 0 |
| FGRRES_09432 | RPN5 | Structural | 18 | 0 |
| FGRRES_06045_M | RPN3 | Structural | 12 | 0 |
| FGRRES_07938 | RPN12 | Structural | 12 | 0 |
| FGRRES_10738 | RPN8 | Structural | 7 | 0 |
| FGRRES_16839 | RPN2 | Structural | 16 | 0 |
| FGRRES_00559_M | RPT1 | ATPase | 10 | 0 |
| FGRRES_02028 | RPT2 | ATPase | 9 | 0 |
| FGRRES_10769 | RPT3 | ATPase | 12 | 0 |
| FGRRES_11597 | RPT5 | ATPase | 12 | 0 |
| FGRRES_09783 | RPN1 | Ubp6 and ubiquitin binding | 17 | 0 |
| FGRRES_00781 | RPN11 | Deubiquitinase | 8 | 0 |
| FGRRES_01123 | RPN10 | Ubiquitin binding | 3 | 0 |
| FGRRES_10724 | - | 26S proteasome regulatory subunit n6 | 1 | 0 |
| Strains | Growth Rate (mm/Day) a,b |
|---|---|
| Bleomycin | |
| PH-1 | 4.06 ± 0.08 c |
| pkr | 1.52 ± 0.10 e |
| Fgblm10 | 4.50 ± 0.30 b |
| FgBLM10∆CT1566 | 5.39 ± 0.05 a |
| Fgblm10 pkr | 0.00 ± 0.00 f |
| FgBLM10∆CT1566pkr | 2.81 ± 0.16 d |
Publisher’s Note: MDPI stays neutral with regard to jurisdictional claims in published maps and institutional affiliations. |
© 2022 by the authors. Licensee MDPI, Basel, Switzerland. This article is an open access article distributed under the terms and conditions of the Creative Commons Attribution (CC BY) license (https://creativecommons.org/licenses/by/4.0/).
Share and Cite
Gong, C.; Xu, D.; Sun, D.; Zhang, X. PKR Protects the Major Catalytic Subunit of PKA Cpk1 from FgBlm10-Mediated Proteasome Degradation in Fusarium graminearum. Int. J. Mol. Sci. 2022, 23, 10208. https://doi.org/10.3390/ijms231810208
Gong C, Xu D, Sun D, Zhang X. PKR Protects the Major Catalytic Subunit of PKA Cpk1 from FgBlm10-Mediated Proteasome Degradation in Fusarium graminearum. International Journal of Molecular Sciences. 2022; 23(18):10208. https://doi.org/10.3390/ijms231810208
Chicago/Turabian StyleGong, Chen, Daiying Xu, Daiyuan Sun, and Xue Zhang. 2022. "PKR Protects the Major Catalytic Subunit of PKA Cpk1 from FgBlm10-Mediated Proteasome Degradation in Fusarium graminearum" International Journal of Molecular Sciences 23, no. 18: 10208. https://doi.org/10.3390/ijms231810208
APA StyleGong, C., Xu, D., Sun, D., & Zhang, X. (2022). PKR Protects the Major Catalytic Subunit of PKA Cpk1 from FgBlm10-Mediated Proteasome Degradation in Fusarium graminearum. International Journal of Molecular Sciences, 23(18), 10208. https://doi.org/10.3390/ijms231810208

